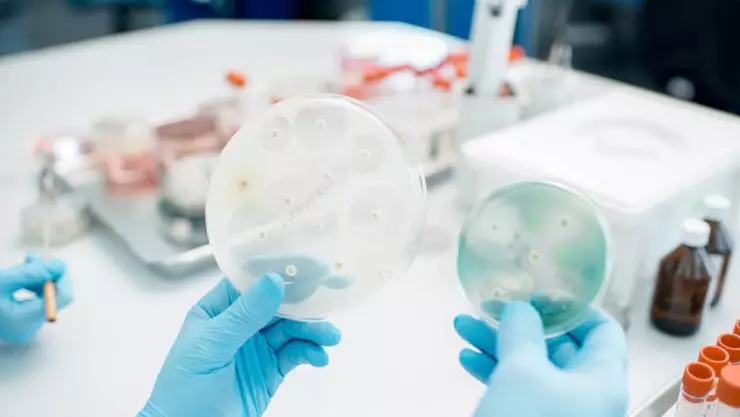
Estreptococo A en Japón

La preocupación está en aumento en Japón debido al creciente número de infecciones graves causadas por el Estreptococo A, una bacteria temida conocida como la "bacteria carnívora". Las autoridades sanitarias del país asiático han emitido una alerta sobre el incremento de casos del síndrome de shock tóxico estreptocócico (STSS), que alcanzó los 378 casos a finales de febrero.
Quizás te interese: VIDEO | Así será el primer parque temático de Dragon Ball en el mundo
Este aumento significativo ha llevado a los expertos a prever que este año podría superarse el número de casos registrados el año anterior, convirtiendo al 2024 en el año con el mayor número de infecciones por Estreptococo A reportadas en Japón hasta la fecha.
#Breaking⚡
— Jesús Rubén Peña (@revistacodigo21) March 19, 2024
Alertó Japón por cepa de bacteria Estreptococo A, también llamada enfermedad carnívora, de rápida propagación y potencialmente mortal, aunque tratable oportunamente con antibióticos.
Bacteria surgió a la par del repunte de COVID y otras enfermedades respiratorias.👇 pic.twitter.com/XUU9lMLaCp
¿Cómo se presenta una infección por Estreptococo A?
Las infecciones por Estreptococo A pueden presentarse de diversas formas, desde casos asintomáticos hasta síndromes de shock tóxico potencialmente mortales. Esta bacteria, perteneciente al grupo A de los estreptococos y específicamente identificada como Streptococcus pyogenes, puede ingresar al cuerpo humano a través de heridas abiertas o mucosas, propagándose incluso por vías respiratorias y pulmones, al igual que el virus del COVID-19.
Quizás te interese: FOTOS | Encuentran cuerpo inhumado clandestinamente en vivienda de Ciudad Juárez
El síndrome de shock tóxico estreptocócico es una complicación peligrosa de la infección por Estreptococo A, con una tasa de mortalidad que puede alcanzar hasta el 30%. Los síntomas incluyen fiebre, escalofríos, dolores musculares, náuseas y vómitos, y la rápida propagación de la infección a través de los tejidos profundos y la sangre.
🇯🇵 | Japón alerta sobre el aumento de casos de una infección grave por estreptococos que puede provocar el síndrome de shock tóxico y la muerte.
— Portal News 🌎 (@inforportalnews) March 18, 2024
Se trata de un estreptococo del grupo A que se transmite a través de las pequeñas gotas de saliva que expulsamos al hablar. Los… pic.twitter.com/Y9DkhVJ7U1
¿Cuáles son los síntomas del Estreptococo A?
Además del STSS, las infecciones por Estreptococo A pueden manifestarse como enfermedades respiratorias, escarlatina, impétigo, fiebre reumática o fascitis necrotizante. Esta última, conocida como la "bacteria carnívora", provoca la muerte del tejido corporal y puede desencadenar el síndrome de shock tóxico.
A pesar de ser considerada una enfermedad rara, los brotes de Estreptococo A no son infrecuentes. En 2022, más de una decena de menores fallecieron en el Reino Unido como resultado de un brote que también afectó a España. Los expertos han señalado varios factores que podrían contribuir al aumento de los casos graves de infección por Estreptococo A, incluida la relajación de las medidas contra el COVID-19 y la creciente resistencia bacteriana a los antibióticos.
Quizás te interese: VIDEO | ¡Ahora fue en la Palestina! Mujer se peleó con cajera de Oxxo
Para esta y más información, síguenos en nuestras redes sociales. En Facebook nos encuentras como Azteca Chihuahua, vía Twitter @aztecachihuahua. Instagram @tvaztecachihuahua o también visita más notas en nuestro sitio web www.aztecachihuahua.com
Quizás te interese: Las tribus se enfrentan por el Collar de Inmunidad Individual | Survivor México 2024